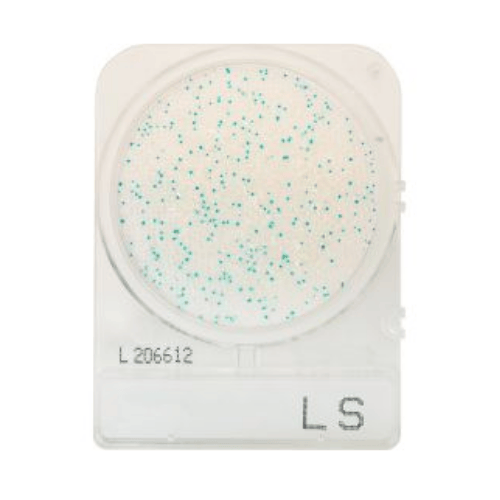
CompactDry™ Listeria spp (LS) Plate

Collections
Shop By Industry
Explore curated products and solutions aligned with the testing, compliance, and operational needs of your industry.

Additional Collections
Featured Products
The Steps You Take Now Shape Our Future
Every step counts when it comes to sustainability. By choosing eco-conscious lab supplies, you're not only reducing waste in your workflow — you're contributing to a more responsible future for science and the planet. Small changes in the lab can lead to meaningful impact.
Who We are
Helping labs reduce waste through vetted, eco-conscious scientific supplies.
With a decade of of experience in scientific distribution, we curate high-quality products from responsible vendors to make sustainable choices easier for biotech, academic, and quality-focused labs.
Businesses around the world are embracing change. Sustainability isn’t all or nothing — it’s a journey. Small shifts like reusable options, lower-impact packaging, and smarter ordering can lead to measurable change.
Education & Resources
Empowering Sustainable Science Through Knowledge
At Go Green Scientific, LLC, we’re more than just a supplier. We’re your partner in creating cleaner, more conscious labs. This space is dedicated to helping you explore the evolving world of sustainable science, from eco-conscious practices to breakthroughs in green innovation.